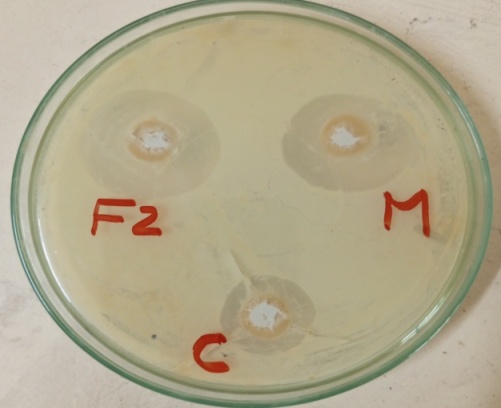

Department of Pharmaceutics, Sri Padmavati Mahila Visvavidyalayam, [Women’s University], Tirupati 517502, Andhra Pradesh [A. P.], India
Email: naveentaj33@gmail.com
Received: 20 Sep 2022, Revised and Accepted: 26 Nov 2022
ABSTRACT
Objective: The objective of the selected study was to develop and statistically optimize fluconazole (drug) loaded pharmacosomes (carrier) to enhance transdermal permeation by incorporating into gel base and to treat fungal infections by selecting the Box-Behnken model.
Methods: Fluconazole is an antifungal drug which belongs to BCS class-II with high permeability and choice for topical drug delivery. In the study, the levels of the lecithin (lipid), dichloromethane and DMSO are selected as independent variables were varied to study the influence on particle size, % entrapment efficiency and in vitro drug release as dependent variables. Factorial designs through software Design expert version 13 (Box-Behnken design) is applied for this study and the optimization process was carried out using the desirability plots and point prediction techniques.
Results: Results of the study with the application of a design expert shows that the optimized drug-loaded pharmacosomes with vesicle size of 158.87±0.56 nm as predicted and zeta potential of-30.6mV indicating good stability of the formulation, entrapment efficiency of 90.6±1.12% and in vitro drug release of 97.59±1.84% respectively. The optimized formulation loaded into gel base and compared with the marketed gel formulation. All the evaluation parameters confirmed that the physical mixture of drug and excipients was compatible without any interactions.
Conclusion: Through obtained results, it’s concluded that; the independent variable plays a crucial role in optimizing formulation. Study data provided strong evidence that the optimized vesicular formulation through Box-Behnken factorial design can be potentially useful as a drug carrier for loading drug of selected category for enhancing transdermal delivery.
Keywords: Fluconazole, Pharmacosomes, Carrier drug delivery, Design expert, Box behenken design, Transdermal gel
© 2023 The Authors. Published by Innovare Academic Sciences Pvt Ltd. This is an open access article under the CC BY license (https://creativecommons.org/licenses/by/4.0/)
DOI: https://dx.doi.org/10.22159/ijap.2023v15i1.46413. Journal homepage: https://innovareacademics.in/journals/index.php/ijap
The novel vesicular system that holds the applications of topical properties plays a major role in designing transdermal drug delivery systems. Several attempts have been proposed to enhance the potential of transdermal drug delivery. Among them, vesicular-based carriers represent a promising concept in which many reported studies state that the drug-loaded carrier has shown more effect than the drug given alone. Generally, the vesicular systems are made of a concentric bimolecular layer which has the capability to encapsulate both non-polar and polar drugs and deliver them into the systemic circulation. Several attempts have been made to enhance drug permeation across the skin, including the use of penetration enhancers, such as fatty acids and organic solvents [1-3]. Moreover, transdermal drug delivery is not suited to all drugs, nor is it justified for all therapies. Most drugs which are administered as transdermal should be small in molecular mass, highly lipophilic, and require small doses. Only a limited number of drugs have been successfully delivered into the skin and implementation of various methods such as iontophoresis, electroporation, sonophoresis, stratumcorneum ablation, microneedles, and chemical enhancers has been investigated and positively concluded that they are helpful in enhancing drug permeation into skin with minimal side effects [4, 5].
Novel carriers, because of their distinct structural and functional features, they can overcome biopharmaceutical challenges generally associated with conventional drug delivery systems like low bioavailability and poor retention and solubility of the drug. Reported literature evidence indicated that the vesicular carriers loaded with drugs exhibited superior therapeutic response with minimum toxicity when compared with conventional dosage forms. It is believed that in the future, the management of precise and concise dose of drug with the highest systemic release from the nanocarriers and minimum toxic effects will not only enhance the use of nanocarrier systems for drug delivery but also improve the patient compliance [6].
Pharmacosomes are part of novel drug delivery systems and are emerging as one of the lipid-based potential vesicular carriers because of their advantages in better stability aspects, increased entrapment efficiency, no drug leakage, and drug-lipid conjugation. It helps to improve the bioavailability and impart better biopharmaceutical properties to the drug. Any drug which posse’s active functional groups like-OH,-NH2, and COOH in their chemical structure is suitable for loading into pharmacosomes. These are zwitterionic, amphiphilic, stoichiometric complexes of polyphenolic compounds with phospholipids. Unlike other lipid-based delivery system, pharmacosomes proven better result in many ways [7].
Gels are semisolid and considered ideal bases when it comes to topical routes of administration, and they often provide a faster release of drug substances. It is independent of the water solubility of the drug when it comes to comparison with creams and ointments. Gel bases are highly biocompatible with a lower risk of irritation, inflammation or adverse reactions and have advantages like easy application and the ability to stay on skin for longer periods of time [8].
For topical treatment of dermatological diseases as well as in skin care, a wide variety of vehicles ranging from solids to semisolids and liquid preparations in many forms are available to clinicians and patients, but among them, topical semisolid dosage form category gels with clear transparency appearance have been most widely accepted in both pharmaceuticals and cosmetics [9]. Topical fungal therapy is usually preferred because of its targeted therapy, fewer side effects, and effective delivery of drugs to the skin. The transdermal route of drug delivery has gained popularity because it avoids first-pass effects, gastrointestinal irritation, and metabolic degradation, which are associated with oral administration [10]. Fluconazole is a BCS class II drug that is used as an antifungal agent for the majority of fungal infections, including superficial and invasive infections. It’s a drug that comes under the imidazole class of synthetic category; it works by slowing the growth of fungi that cause infection. Due to the first-pass effect, only 25-45% of the orally administered dose of fluconazole reaches the systemic circulation. In order to overcome these drawbacks, the gel formulations have been proposed as a topical application for the selected drug [11].
The aim of selected research work is to formulate fluconazole-loaded pharmacosome gel with selected solvents and permeation enhancers to enhance the drug permeation rate into the skin and to treat the fungal infection with the application of design expert Version 13, Stat-Ease Inc. (Minneapolis, USA) by selecting Box-behnken design.

Fig. 1: Structure of fluconazole
Materials
Fluconazole drug, Carbopol 940, Egg phosphatidylcholine was purchased from himedia chemicals. All the solvents and chemicals used in the experiment process were of analytical grades. For antifungal study Candida albicans strain was procured from SVIMS Microbiology Dept. Tirupati.
Experimental methods
Method of preparation of fluconazole-loaded pharmacosomes by solvent evaporation method
Fluconazole-loaded pharmacosomes were prepared by taking varying ratios of selected drugfluconazole and lipid-soya lecithin and it is dissolved in dichloromethane and few ml of dimethyl sulfoxide and placed in 100 ml round bottom flask and itssubjected tosolventevaporationmethod using rotary flash evaporator for a period of 45 min and a thin film is formed around the round bottom flask. Then it was hydrated with solution of phosphate buffer of pH 7.4. After hydration with buffer solution a thick vesicular suspension will be formed, which can be subjected to lyophilisation and dried powder or residues were collected and placed in vacuum desiccators for three days and then subjected to characterization [12, 13].
Experimental design for the formulation of fluconazole-loaded pharmacosomes
The optimization of fluconazole-loaded pharmacosomes was done by Design Expert, Version 13, Stat-Ease Inc. (Minneapolis, USA) using three factors at three levels. It provides a rationale for understanding the possible interaction(s) among both independent and dependent variables and helps in selecting best and optimum formulation in lesser experimental time. The design will help to identify the positive or negative effect of a different variable on desired responses. Lecithin (mg), Dichloromethane (ml), DMSO (ml) taken as the three independent variables as factors (X1,X2, X3) and the amount of drug was kept constant in the selected procedure. Particle size (nm), entrapment efficiency (%), in vitro drug release (%) taken as the dependent variables as responses (Y1,Y2,Y3). These independent variables varied at three different levels, low level (-1), medium level (0), and high level (+1).
Three different models usually opted in the design expert for the study either it may be Linear, quadratic and cubic models which are used to describe the levels of relationship between dependent and independent variables. Numerous statistical parameters, consisting of the p-value of the model, ANOVO F-value, p-value of lack of fit, multiple regression coefficients (R2), adjusted multiple regression coefficients (adjusted R2), coefficient of variation, was considered to select a suitable fitting model. The terms with p-value greater than 0.0005 were considered as insignificant and were not suitable for the model. Each response parameter was evaluated by quadratic model using multiple regression analysis by generating the equations through software. Generally, in this selected experimental study Box-Behnken model was selected, in which by selecting a second-order quadratic polynomial equation, generating 2D and 3D contour plot represents the relationship between variables and desired responses in the form of graphical representations [14, 15].
Experimental factorial design: box behnken model
Through preliminary screening, the concentration of lipid, solvent and chemical enhancer were identified as the significant variables within the selected range of 100-200 mg lipid, 10-20 ml and 0.5-1.5 ml concentrations.
Table 1: Factorial design selection and optimization of ingredients
| Factor | Name | Low level | Medium level | High level |
| A | LECITHIN | 150.00 | 100.00 | 200.00 |
| B | DCM | 15.00 | 10.00 | 20.00 |
| C | DMSO | 1.0000 | 0.5000 | 1.50 |
Along with second order quadratic polynomial equations, statistical Analysis of variance (ANOVA) was also applied to determine the significance and the magnitude of the original effects of each variable and their interactions. Counterplots are generated for independent factors. The ANOVA table establishes the sufficiency of the model (i.e., p<0.05). Through the obtained results of the p-value which is less than 0.05 for all the response factors indicative of that the models are significant. By comparing the experimental and predicted responses the data showed that most of the predicted values are nearly similar to the experimental values. This indicates the excellent ability of the experimental design employed for the optimization of pharmacosome formulation of fluconazole. The predicted R2values were in agreement with the adjusted R2values for all the responses. The relationship between the dependent and independent variables was further studied using 2D contour plots and 3D response surface plots. Desirability and graphical optimization technique were utilized for generating formulation with the desired responses. The 3D response surface plots are useful to understand the effect of interactions and effects between the factors on an each individual response [16].
Preparation of fluconazole loaded pharmacosome (FZ-PC) transdermal gel
Carbopol 940p of different concentrations were prepared like (0.5, 0.75, 1.0, 1.5, 2.0% w/w) and dissolved in required quantity of water which is taken in a 100 beaker and allowed to soak for a period of 24 h. To this previously formulated fluconazole loaded pharmacosomes best formulation (100 mg) was dispersed in few ml of alcohol and also same quantity (100 mg) of pure drug was taken for comparison andadded into gel formulations in this process alcohol acts as distributing agent. Final makeup ofgel was then neutralised with sufficient quantity of triethanolamine, glycerine, methyl and propyl paraben. Glycerine as moisturizing agent and emollient, methyl and propyl paraben as preservatives added slowly with continuous stirring until the homogenous clear gel was formed [17, 18].
Evaluation of gel
Drug content
Weighed quantity 10 gm of each gel formulation were transferred into a 250 ml of conical flask containing 20 ml of alcohol and stirred for a time period of 30 min. The volume was made up to 100 ml final and filtered. Sample aliquots were prepared by taking 1 ml of abovesolution was further diluted to 10 ml with alcohol andagain from this 1 ml of the solution was further diluted to 10 ml with alcohol. The absorbance of the solution was measured by using a spectrophotometer at 260 nm and drug content was calculated by using the formula [19, 20].
Drugcontent =
x Dilution factor x 
Table 2: Formulation of FZ-PC loaded transdermal gel
| Ingredients | F1 | F2 | F3 | F4 | F5 |
| Pure drug Fluconazole (mg) | 100 | 100 | 100 | 100 | 100 |
| FZ-PC(mg) | 100 | 100 | 100 | 100 | 100 |
| Carbopol(%) | 0.5 | 0.75 | 1.0 | 1.5 | 2.0 |
| Alcohol(ml) | 3.5 | 3.5 | 3.5 | 3.5 | 3.5 |
| Propyl paraben(gm) | 0.1 | 0.1 | 0.1 | 0.1 | 0.1 |
| Methyl paraben(gm) | 0.05 | 0.05 | 0.05 | 0.05 | 0.05 |
| Triethanolamine(ml) | 4 | 4 | 4 | 4 | 4 |
| Glycerine (ml) | 10 | 10 | 10 | 10 | 10 |
| Water (ml) | 65 | 65 | 65 | 65 | 65 |
Spreadability
The spreadability of the gel formulation was determined 48 h after preparing the gel samples and it can be done by measuring the spreading diameter of 10 g of the gel between two glass slides after 60 sec. The mass of the upper plate was standardized at 20 g, placing slides one above the other and counting the time taken for the 2nd slide to slip out from another slide. Lesser the less time is taken for the separation of two slides, the better the spreadability. It is determined by the formula given below [21].
Spreadability=M x 

Where S=Spreadability (g. cm/s), M = weight tied to the upper slide (20 g), l= length of glass slide (6 cms), t = time taken is sec.
pH measurement
The pH measurements of the all the prepared gel formulations were carried out using a standard digital pH meter by dipping the glass electrode completely into the gel formulation to cover the electrode and all the prepared formulations were measured and the values in taken in average of triplicate times [22].
In vitro drug release
The in vitro drug release studies of fluconazole-loaded pharmacosome gel formulation were studied using Franz diffusion cell. The in vitro diffusion of the drug was performed through one end of the hollow glass tube which acts as donor compartment 10 ml of 7.4 pH phosphate buffer saline was taken in a beaker which was placed in a receptor compartment. The weighed quantity was uniformly spread on the dialysis membrane. The donor compartment was kept in contact with the receptor compartment and the temperature was maintained at 37±0.5 °C. The solutions of the receptor side were stirred by a small magnetic bead and were rotated at a constant speed. At predetermined time intervals, samples were withdrawn and the same amount was replaced by 5 ml of PBS. The drug concentrations in the aliquot were analyzed for the amount of drug released using a UV spectrophotometer at 260 nm against appropriate blank [23-25].
Kinetic Modelling for prepared formulations
In view to study the release kinetics and % drug release, data obtained from in vitro studies of gel formulations were fitted into different kinetic models such as Zero Order, First Order, Higuchi model and Korsmeyer-Peppas model. For determining various purposes like to know about the order of release, the % drug release data was fitted to zero order and first order plots and for drug release mechanism the data was fitted to Higuchi model. To confirm the drug release mechanism data was fitted to the Korsmeyer-Peppas model [26, 27].
Zero-order model: Q t = Q 0+K 0 t
First order model: log C = log C 0 n K t/2.303
Higuchi model: f t = Q = K H x t 1/2
Korsmeyer-Peppas model: M t/M ∞ = Kt.
Table 3: Composition of SDA medium
| S. No. | Ingredients | Quantity (g/l) |
| 1 | Dextrose | 40g |
| 2 | Peptone | 10g |
| 3 | Agar | 18g |
| 4 | Distilled Water | 1000 ml |
| 5 | pH | 5.7 |
Table 4: Experimental runs, independent variables, and measured response Box-Behenken design for fluconazole loaded pharmacosomes
| Factor 1 | Factor 2 | Factor 3 | Response 1 | Response 2 | Response 3 | ||
| Std | Run | A: Lecithin mg | B: DCM ml | C: DMSO ml | PS* nm | EE* % | IDR* % |
| 5 | 1 | 100 | 15 | 0.5 | 165.03±0.32 | 79.99±0.59 | 95.23±1.52 |
| 7 | 2 | 100 | 15 | 1.5 | 158.87±0.56 | 90.6±1.12 | 97.59±1.84 |
| 15 | 3 | 150 | 15 | 1 | 169.9±0.49 | 72.51±1.53 | 89.25±0.73 |
| 10 | 4 | 150 | 20 | 0.5 | 181.73±0.89 | 59.1±1.25 | 86.84±0.69 |
| 14 | 5 | 150 | 15 | 1 | 197±1.11 | 85.67±0.89 | 94.08±1.62 |
| 3 | 6 | 100 | 20 | 1 | 156.49±0.69 | 87.1±0.92 | 96.87±1.71 |
| 9 | 7 | 150 | 10 | 0.5 | 88.2±1.29 | 52.89±1.18 | 61.06±0.89 |
| 6 | 8 | 200 | 15 | 0.5 | 185.28±0.98 | 79.52±0.23 | 94.92±1.69 |
| 12 | 9 | 150 | 20 | 1.5 | 134.2±0.78 | 73.51±0.42 | 69.52±1.12 |
| 2 | 10 | 200 | 10 | 1 | 129.48±1.01 | 79.65±0.54 | 95.41±1.69 |
| 4 | 11 | 200 | 20 | 1 | 212.24±2.10 | 79.3±0.52 | 92.96±0.89 |
| 8 | 12 | 200 | 15 | 1.5 | 216.6±2.12 | 88.4±0.90 | 96.95±1.72 |
| 1 | 13 | 100 | 10 | 1 | 129.3±0.37 | 59.02±1.25 | 79.93±1.01 |
| 11 | 14 | 150 | 10 | 1.5 | 127.97±0.35 | 54.95±0.55 | 85.96±0.09 |
| 13 | 15 | 150 | 15 | 1 | 193.5±0.59 | 79.78±0.13 | 92.83±0.49 |
*Data represent mean±SD, (n = 3)
Antifungal study
As per the standard formula, weighed quantity of 16.25 gms of sabouraud dextrose agar transferred into a 500 ml of conical flask and to this 250 ml of distilled water is added and then subjected to a heating process to dissolve it completely for 15 min and then it is subjected to sterilization at 121 °C at 15 lb pressure in autoclave for 20 min. Then it is cooled at normal room temperature and the selected fungal strain candida albicans dispersed in the prepared medium and medium quantity is divided into Petri dish and with the help of sterile steel bore of 6 mm the calculated concentrations of the optimized pure drug fluconazole gel, fluconazole loaded pharmacosome gel (F3), marketed gel as a standard were placed in the bores and incubated for 72 h at 37 °C. After the completion of time period zone of inhibition was observed and the radius of the inhibition was calculated [28, 29].
Effect of lipid, solvent and permeation enhancer on Particle Size (nm) (Response 1)
In particle size determination, lipid concentration plays a major role as the concentration of lipid increases the particle size tends to increases and obtained values ranges in between minimum to maximum of 88.6 nm to 216.6 nm for the total 15 experimental runs. Thefirst independent variable which is particle size when subjected to second order quadratic models it has shown result that the Model F-value of 15.20 which implies the model is significant and there is only a 0.40 % chance that an F-value this large could occur due to noise. The result of P-values is 0.0040 (Significant) P values less than 0.0500 indicates the model terms are significant. Generally values greater than 0.100 indicates the model terms are not significantbut in this case A, B, BC, B2 are significant model terms within limits. The Predicted R² of 0.7630 is in reasonable agreement with the Adjusted R² of 0.9012; i.e. the difference is less than 0.2. The Positive sign in polynomial coded equation for particle size indicates there is good compatibility between factors and responses [30].
Final equation in terms of coded factors
PS=+186.80+16.74A+26.21B+2.17C+13.89AB+9.37AC-21.83BC+9.25A2-39.17B2-14.60C2
Where A= lipid Concentration (mg) B= Solvent (ml) C=DMSO (ml)
Here ‘+’ and ‘–’ sign indicates positive, negative effects towards the response parameter
Here in case of particle size, the selected factors like lipid,solvent,DMSO concentration showed positive effect towards the response variable PS, from the equation+186.80 indicatescoefficient estimate and with increase in the lipid concentration there is increase in the particle size. Out of total 15 experimental runs with lipid concentration level of 100 mg (F1,F2,F6,F13-165.03 nm, 158.87 nm, 156.49 nm, 129.3 nm) withlipidlevel 150 mg (F3,F4,F5,F14,F15-169.9 nm, 181.73 nm, 197 nm, 127.97 nm, 193.5 nm) with lipid level 200 mg (F8,F10,F11,F12-185.28 nm,129.48 nm,212.24,216.6 nm). Out of these three lipid levels of 100 mg has shown minimum particle size when compared with remaining two levels. Withincrease in the combination of solvent and DMSO levels,this leads to decrease in particle size. Thereby it’s concluded along with lipid concentration the solvent also taken a major role in determining particle size and furthered study supported by Al-Mahallawi et al. [31].
![]() |
![]() |
Fig. 2: Particle size 2D contour,3D surface contour and cube plots(Box-Behnken)
Effect on entrapment efficiency (%) (Response2)
Effect of selected ingredients on % EE shows, the concentration of lecithin out of threelevels of (100,150,200 mg) the highest %loading efficiency was observed with lower concentration of lecithin and with increased concentration of DMSO. The formulation code F2 with composition of lipid: solvent: DMSO with 100:15:1.5 has shown highest 90.6% entrapment drug release efficiency which was selected as optimized considering the role of solvent ratio also. Total 15 experimental runs was obtained with three central points in which entrapment efficiency was found to be minimum to maximum release efficiency of 52.89 to 90.6% its concluded that low levels of lipid and high level of permeation enhancer shows highest release rate. Along with second order quadratic equation it was subjected to ANOVO analysis to find out result of P and F values in which P-value is 0.0111 and the model F-value is 9.69 implies the model is significant and there is only a 1.11% chance that an f value this large could occur due to noise. The P value less than0.0500 indicates model terms are significant. In this case B, C, AB,A2,B2 are significant model terms. The Predicted R² of 0.6762 is in reasonable agreement with the Adjusted R² of 0.8482; i.e. the difference is less than 0.2. The positive sign in coded factors of polynomial equation results that good interactions between factors and responses [14].
Final equation in terms of coded factors
%EE= 79.32+1.27A+6.56B+4.50 C-7.11AB-0.4325AC+3.09BC+10.73 A²-13.78 B²-5.42 C²
Where A= lipid Concentration (mg) B= Solvent (ml) C=DMSO (ml)
Through the obtained results it was found to be, 79.32 is the coefficient estimate that the concentration of lecithin and dichloromethane and DMSO were showing a positive effect on entrapment efficiency at optimum concentration. The %entrapment efficiency of pharmacosomes was increased with low concentration of lipid in the formulation F2 which shows highest % EE of 90.6% and decreases with increases in the lipid concentrationwhich can be observed in formulation F7 with only 52.89 %EE. This may be due to the agglomeration of particles and the formation of larger particles with increase in lipid concentration. Along with lipid concentration, the ratio of solvents and DMSO also plays major role in getting the highest percentage release of EE [32].
![]() |
![]() |
Fig. 3: % Entrapment efficiency 2D contour and 3D surface contour plots (Box-Behnken)
Effect on in vitro drug release % (Response3)
Effect of selected ingredients like lecithin, solvent and permeation enhancer DMSO shows that a higher concentration of DMSO shows good drug releases. Higher the concentration of DMSO more the drug release. In this study concentration of solvents and DMSO are directly proportionate to drug release. Hence, the selected study is based on enhancing the permeation of the drug through the skin by the addition of permeation enhancers, through software predicted values proved the composition with 1.5 value shows highest release of 97.6%. Outcome of the data in comparison [14]. Result of P and F values in which the result of P-values is 0.0014 (Significant) the F-value is 24.00 implies the model is significant and there is only a 0.14% chance that an F value this large could occur due to noise. In this case, B, AB, BC, A2, B2, C2 are significant model terms. The Predicted R² of 0.7444 is in reasonable agreement with the Adjusted R² of 0.9366; i.e. the difference is less than 0.2.
Final equation in terms of coded factors
IDR= 92.05+1.33A+2.98B+1.50C-4.85AB-0.0825AC-10.55BC+9.78 A²-10.54 B²-5.66 C²
Where A= lipid Concentration (mg) B= Solvent (ml) C=DMSO (ml)
Here ‘+’ and ‘–’ sign indicates positive and negative effects towards the response parameter
As per the second-order quadratic polynomial equation, the lipid, solvent and permeation enhancer DMSO concentration is showing a positive effect on in vitro drug release. The result showed that the% release of drug in pharmacosomes was increased with an increase in the concentration of lipid and solvent [33]. Based on this formulation F2 with soya-lecithin (100 mg), dichloromethane (15 ml) and DMSO (1.5 ml) has shownhighrelease of 97.59%, whereas formulation F7 with lipid: DMSO concentration of 150 mg: 0.5 ml has shown only 61.06% of drug release.
![]() |
![]() |
Fig. 4: In vitro drug release 2D contour plots and 3D surface contour plots (Box-Behnken)
![]() |
![]() |
Fig. 5: SEM image of optimized formulation (F2)
Selection of the optimum formula
In the continuation to the process for selection of the best formulation, further in the study point prediction method of Box-Behnken model was applied for the optimization of pharmacosomes formulation. The optimized formula desirability function values lessthanand near to 1 confirms the suitability of the formulations [34]. The optimized formulation so produced will be further evaluated for SEM, FT-IR, DSC to determine the physical interactions between the selected components i.e., drug, lipid, solvent mixture. The optimized formulation basis on these parameters were selected and loaded into the gel base.
SEM analysis
SEM morphology of optimized formulation(F2) with the composition of drug and solvent mixture revealed the shape and size of the particles with spherical smooth surfaces ranging minimum size particles without any agglomerates [15].
FT-IR analysis
FTIR studies of optimized formulation when compared with pure drug found to be nearer to wavelength of same functional groups in their spectra, reveals that the drug and excipients are compatible without any interactions and selected drug, excipients and solvents are compatible in the physical mixture.
The possible interactions between the drug and the excipients were studied by IR spectroscopy. From the FT-IR study, the characteristic peaks of drugs such as free OH stretching at (3321.45), CH2 stretching (2873.20), CH Aromatic stretching at (3051.52), C=N stretching (1620.1), CH Aromatic blending (1456), C-F stretch (669.93) appeared for pure drug fluconazole. For optimized formulation, F2 of pharmacosome mixture of all peaks which have been obtained for the pure drug were similar at near wavelength for free OH stretch (3336.88), free OH stretching at (3780.3), CH2stretching (2969.01), CH Aromatic stretching at (3185.55), C=N stretching (1596.47), CH Aromatic blending (1437.98), C-Fstretch (636.46), appearances of remaining peaks also either shifted or replaced in the IR spectrum [11]. The FT-IR spectra of drug and their physical mixtures with drug and excipients there was no major shifting as well as loss of any functional peaks between the spectra of drug and physical mixtures as shown in the (fig. 6). Hence, it was confirmed that there are no interactions between the drug and the selected excipients. This finding was further supported by remaining follow-up studies.
![]() |
![]() |
Fig. 6: FT-IR images of pure drug and optimized formulation (F2)
Table 5: % Drug content for FZ-PC and pure drug formulations (F1-F5)
| Formulation code | % Drug content |
| FZ-PC gel | |
| F1 | 94.0±0.037 |
| F2 | 95.8±0.037 |
| F3 | 97.5±0.019 |
| F4 | 95.0±0.041 |
| F5 | 93.0±0.039 |
*Data represent mean±SD, (n = 3)
Drug content
The percentage drug content of all gel-prepared formulations i.e. F1 to F5 was found to be in the range of 93±0.039 to 97.5±0.019 % and F3 was found to be the highest release [19] with 97.5% shown in (table 5) and the pure drug gel also ranges between 91±0.042 to 96.7±0.029.
Spreadability
The spread-ability of the fluconazole-loaded prepared gel formulations after 60 seconds was determined in which out of five formulations, F3 has shown good spreading ability within the selected area in less time with 23.28±1.14. In the same way all the formulation subjected and calculated using the formula and values was compared and noted in (table 6) and the outcome of data supported by vyas p et al. [35].
Table 6: % Spreadability of FZ-PC gel formulations (F1-F5)
| Formulation code | Spreadability (gm. cm/sec) |
| F1 | 18.78±1.68 |
| F2 | 20.50±1.22 |
| F3 | 23.28±1.14 |
| F4 | 22.01±0.71 |
| F5 | 21.00±0.95 |
*Data represent mean±SD, (n = 3)
pH
The pH was evaluated with a standard pH meter for all the prepared formulations (F1-F5) and the values varies between 6.52±0.20 to 6.82±0.17 and the marketed gel formulation was taken as standard for the comparison procedure [22] and the value was found to be 6.90±0.11which indicates all obtained values are within the acceptable range which is depicted in the (table 7)
In vitro drug release
In vitro drug release for the prepared gel formulations (F1-F5) shows a release rate from 77.02% to 94.05% at the end of 8 h [24, 36]. Among five formulations, F3 obtained highest % drug release at the end of 8 h with 94.05±0.03 and considered as best formulation based on the release. Then the comparison of % release between fluconazole loaded gel, pure drug gel and marketed formulation results shows that FZ-PC with 94.05±0.03, marketed gel with 92.32±0.12, pure drug gel with 89.95±0.18drug release. The % release rates of all five formulations have mentioned in the (table 8).
Table 7: pH of FZ-PC gel formulations (F1-F5)
| Formulation code | pH |
| F1 | 6.52±0.20 |
| F2 | 6.54±0.21 |
| F3 | 6.82±0.17 |
| F4 | 6.65±0.19 |
| F5 | 6.67±0.18 |
*Data represent mean±SD, (n = 3)
Table 8: % in vitro release of FZ-PC gel formulations (F1-F5)
| Time (H) | % Drug release |
| F1 | |
| 0 | 0 |
| 1 | 25.46±0.54 |
| 2 | 42.25±0.98 |
| 3 | 41.60±0.10 |
| 4 | 46.75±0.64 |
| 5 | 48.50±0.12 |
| 6 | 55.75±0.01 |
| 7 | 61.54±0.02 |
| 8 | 70.01±0.03 |
*Data represent mean±SD, (n = 3)

Fig. 7: In vitro release plots for FZ-PC gels (F1-F5)

Fig. 8: In vitro drug release comparison of pure drug gel, FZ-PC gel, marketed gel
![]() |
![]() |
![]() |
![]() |
Fig. 9: kinetics models graphs for optimized formulation FZ-PC gel (F3)
Table 9: In vitro release kinetic model data of FZ-PC gel formulation (F3)
Formulation code |
R2 values | n-value |
| Zero order | First order | |
| F3 | 0.968 | 0.920 |
In vitro drug release obtained of optimized formulation was fitted to different kinetic models like zero order, first order, Huguchi, and Korsmeyer-Peppas model to know the drug release mechanism from formulations. The optimized formulation follows best fit with Huguchi model kinetics with the highest R2=0.977 and Korsmeyer-Peppas showed good linearity with a regression R2 value of 0.968 suggested that release mechanism was diffusion controlled and n value of 0.593 indicates Anomalous (non-fiction) diffusion drug release mechanism. It indicates the characteristics of those cases where in addition to the diffusion, other mechanisms to contribute the to release of the drug [27].
Antifungal study
Anti-fungal studies also showed the good results with an optimized formulation of FZ-PC loaded gel (F3) in sabouraud dextrose agar with the maximum zone of inhibition of 7.1±0.14, when compared with pure drug gel6.7±0.22 and marketed gel formulation6.9±0.12which are considered as standard in the procedure and this is in findings of Niyaz Basha et al. [11]. This study signifies the potential of pharmacosome gel for topical delivery of fluconazole and can observe that sustained release of drug could maintain the localized effect, resulting in effective treatment of a life-threatening cutaneous fungal infection [37, 38].

Fig. 10: Comparison of zone of inhibition (n=3)
Table 10: Zone of inhibition comparison of optimized, pure and marketed gel
| Formulations | Zone of inhibition (mm) |
| optimised pure drug gel (F3)-Control | 6.7±0.22 |
| FZ-PC gel | 7.1±0.14 |
| Marketed gel (flucos 0.5%) | 6.9±0.12 |
*Data represent mean±SD, (n = 3)
In this current research, an effort was made through an experimental design approach to optimize and formulate fluconazole-loaded pharmacosomes. The box-Behnken factorial design was used to analyse the effect of interactions between responses and factors with selected variables like particle size, encapsulation efficiency, and in vitro drug release. The experiment was carried out with three central points with 15 experimental runs in which F2 is considered as best formulation which showed optimum particle sizeof 158.87±0.56 nm; highest %EE 90.6±1.12 and %drug release of 97.59±1.84. Then optimized formulation loaded into carbopol gel base and subjected to characterization, it shows all the parameters results falls within the standard limits. Based on the findings, it was concluded that fluconazole-loaded pharmacosome gel can potentially be used to treat fungal infections with a sustained release effect, the highest loading efficiency and more drug release rate, and superior antifungal activity when compared to pure drug gel and marketed gel formulation, which are considered as standard. The study revealed that thepharmacosome is a promising carrier for the drug delivery of fluconazole.
Authors are thankful to Sri Padmavati Mahila University for providing facilities to carry out research work.
Nil
All the authors have equally contributed to this manuscript.
The authors declare no conflict of interest.
Abd El-Alim SH, Kassem AA, Basha M, Salama A. Comparative study of liposomes, ethosomes and transfersomes as carriers for enhancing the transdermal delivery of diflunisal: in vitro and in vivo evaluation. Int J Pharm. 2019;563:293-303. doi: 10.1016/j.ijpharm.2019.04.001. PMID 30951860.
Morilla MJ, Romero EL. Ultradeformable phospholipid vesicles as a drug de-livery system: a review. Res Rep Transder Drug Deliv. 2015;4:55-69.
Elsayed MM, Abdallah OY, Naggar VF, Khalafallah NM. Lipid vesicles for skin delivery of drugs: reviewing three decades of research. Int J Pharm. 2007 Mar 6;332(1-2):1-16. doi: 10.1016/j.ijpharm.2006.12.005. PMID 17222523.
Touitou E, Dayan N, Bergelson L, Godin B, Eliaz M. Ethosomes-novel vesicular carriers for enhanced delivery: characterization and skin penetration properties. J Control Release. 2000 Apr 3;65(3):403-18. doi: 10.1016/s0168-3659(99)00222-9, PMID 10699298.
Monti D, Egiziano E, Burgalassi S, Tampucci S, Terreni E, Tivegna S, Chetoni P. Influence of a combination of chemical enhancers and iontophoresis on in vitro transungual permeation of nystatin. AAPS PharmSciTech. 2018 May;19(4):1574-81. doi: 10.1208/s12249-018-0977-4.
Din FU, Aman W, Ullah I, Qureshi OS, Mustapha O, Shafique S. Effective use of nanocarriers as drug delivery systems for the treatment of selected tumors. Int J Nanomedicine. 2017 Oct 5;12:7291-309. doi: 10.2147/IJN.S146315. PMID 29042776, PMCID PMC5634382.
Semalty A, Semalty M, Rawat BS, Singh D, Rawat MS. Pharmacosomes: the lipid-based new drug delivery system. Expert Opin Drug Deliv. 2009 Jun;6(6):599-612. doi: 10.1517/17425240902967607, PMID 19519287.
Kasar PM, Kale K, Phadtare DG. Formulation and evaluation of topical antifungal gel containing itraconazole. Int J Curr Pharm Sci 2018;10(4). doi: 10.22159/ijcpr.2018v10i4.28470.
Raphael AP, Garrastazu G, Sonvico F, Prow TW. Formulation design for topical drug and nanoparticle treatment of skin disease. Ther Deliv. 2015 Feb;6(2):197-216. doi: 10.4155/tde.14.106, PMID 25690087.
El-Housiny S, Shams Eldeen MA, El-Attar YA, Salem HA, Attia D, Bendas ER. Fluconazole-loaded solid lipid nanoparticles topical gel for the treatment of pityriasis versicolor: formulation and clinical study. Drug Deliv. 2018 Nov;25(1):78-90. doi: 10.1080/10717544.2017.1413444, PMID 29239242.
NiyazBasha B, Kalyani P, Divakar G. Formulation and evaluation of gel containing fluconazole-antifungal. Int J Drug Dev Res. 2011;3:109-12.
Hardikar SR, Mulla SS. Optimization of formulation of solid dispersion of furosemide by factorial design. Int J Pharm Pharm Sci. 2020 Apr;12(4):43-8. doi: 10.22159/ijpps.2020v12i4.36428.
Yue PF, Zheng Q, Wu B, Yang M, Wang MS, Zhang HY. Process optimization by response surface design and characterization study on geniposide pharmacosomes. Pharm Dev Technol. 2012 Jan-Feb;17(1):94-102. doi: 10.3109/10837450.2010.516439, PMID 20919929.
Gupta N, Jain S. Designing and optimization of naproxen sodium deformable vesicular systems through factorial design: box behenken model. Int J App Pharm. 2021;13:190-7. doi: 10.22159/ijap.2021v13i2.40398.
Deka T, Das MK, Das S, Das P, Singha LR. Box-behnken design approach to develop nano-vesicular herbal gel for the management of skin cancer in an experimental animal model. Int J App Pharm. 2022;14(6):148-66. doi: 10.22159/ijap.2022v14i6.45867.
Soliman SM, Abdelmalak NS, El-Gazayerly ON, Abdelaziz N. Novel nonionic surfactant proniosomes for transdermal delivery of lacidipine: optimization using 23 factorial design and in vivo evaluation in rabbits. Drug Deliv. 2016;23(5):1608-22. doi: 10.3109/10717544.2015.1132797, PMID 26758033.
Singh MP, Nagori BP, Shaw NR. Formulation development and evaluation of topical gel formulations using different gelling agents and its comparison with marketed gel formulation. Int J Pharm Erud. 2013;3:1-10.
Grace XF, KS, SS. Development of terminalia chebula loaded ethosomal gel for transdermal drug delivery. Asian J Pharm Clin Res 2018;11(12). doi: 10.22159/ajpcr.2018.v11i12.20764.
Sudipta DA, Arnab SA, Ananya BO. Design, development and evaluation of fluconazole topical gel. Asian J Pharm Clin Res. 2015;8:132-13.
Jain S, Padsalg BD, Patel AK, Mokale V. Formulation, development and evaluation of fluconazole gel in various polymer bases. Asian J Pharm. 2017;1:3-8. doi: 10.22377/ajp.v1i1.742.
Loveleenpreet K, Prabhjot K. Formulation and evaluation of topical gel of meloxicam. Int J Res Pharm Chem. 2014;4:619-23.
Das S, Samanta A, Bose A. Design, development and evaluation of fluconazole topical gel. Asian J Pharm Clin Res. 2015;8:132-5.
Kasar PM, Kale K, Phadtare DG. Formulation and evaluation of topical antifungal gel containing itraconazole. Int J Curr Pharm Sci. 2018;10(4):71-4. doi: 10.22159/ijcpr.2018v10i4.28470.
Kasar PM, Kale K, Phadtare DG. Formulation and evaluation of topical antifungal gel containing itraconazole. Int J Curr Pharm Sci 2018;10(4). doi: 10.22159/ijcpr.2018v10i4.28470.
Kikwai L, Babu RJ, Prado R, Kolot A, Armstrong CA, Ansel JC. In vitro and in vivo evaluation of topical formulations of spantide II. AAPS PharmSciTech. 2005 Oct 31;6(4):E565-72. doi: 10.1208/pt060471, PMID 16408858, PMCID PMC2750604.
Siepmann J, Peppas NA. Modeling of drug release from delivery systems based on hydroxypropyl methylcellulose (HPMC). Adv Drug Deliv Rev. 2001 Jun 11;48(2-3):139-57. doi: 10.1016/s0169-409x(01)00112-0, PMID 11369079.
Costa P, Sousa Lobo JM. Evaluation of mathematical models describing drug release from estradiol transdermal systems. Drug Dev Ind Pharm. 2003 Jan;29(1):89-97. doi: 10.1081/ddc-120016687, PMID 12602496.
Liu S, Hou Y, Chen X, Gao Y, Li H, Sun S. Combination of fluconazole with non-antifungal agents: a promising approach to cope with resistant Candida albicans infections and insight into new antifungal agent discovery. Int J Antimicrob Agents. 2014 May;43(5):395-402. doi: 10.1016/j.ijantimicag.2013.12.009. PMID 24503221.
Bhalaria MK, Naik S, Misra AN. Ethosomes: a novel delivery system for antifungal drugs in the treatment of topical fungal diseases. Indian J Exp Biol. 2009 May;47(5):368-75. PMID 19579803.
Moolakkadath T, Aqil M, Ahad A, Imam SS, Iqbal B, Sultana Y. Development of transethosomes formulation for dermal fisetin delivery: box-behnken design, optimization, in vitro skin penetration, vesicles-skin interaction and dermatokinetic studies. Artif Cells Nanomed Biotechnol. 2018;46Suppl:755-65. doi: 10.1080/21691401.2018.1469025, PMID 29730964.
Al-Mahallawi AM, Abdelbary AA, Aburahma MH. Investigating the potential of employing bilosomes as a novel vesicular carrier for transdermal delivery of tenoxicam. Int J Pharm. 2015;485(1-2):329-40. doi: 10.1016/j.ijpharm.2015.03.033. PMID 25796122.
Garg V, Singh H, Bhatia A, Raza K, Singh SK, Singh B. Systematic development of transethosomal gel system of piroxicam: formulation optimization, in vitro evaluation, and ex vivo assessment. AAPS PharmSciTech. 2017;18(1):58-71. doi: 10.1208/s12249-016-0489-z, PMID 26868380.
Alhakamy NA, Aldawsari HM, Ali J, Gupta DK, Warsi MH, Bilgrami AL. Brucine-loaded transliposomes nanogel for topical delivery in skin cancer: statistical optimization, in vitro and dermatokinetic evaluation. 3 Biotech. 2021;11(6):288. doi: 10.1007/s13205-021-02841-5, PMID 34109091.
Muralikrishna P, Babu AK, Mamatha P. Formulation and optimization of Ceritinib loaded nanobubbles by box-Behnken design. Int J Appl Pharm. 2022;14:219-26.
Vyas J, Vyas P, Raval D, Paghdar P. Development of topical niosomal gel of benzoyl peroxide. Nanotechnology. 2011;2011:1-6. doi: 10.5402/2011/503158.
Azizah N, Sagita E, Iskandarsyah I. In vitro penetration tests of transethosome gel preparations containing capsaicin. Int J Appl Pharm. 2017;9:116. doi: 10.22159/ijap.2017.v9s1.68_75.
Baghel S, Nair VS, Pirani A, Sravani AB, Bhemisetty B, Ananthamurthy K. Luliconazole-loaded nanostructured lipid carriers for topical treatment of superficial tinea infections. Dermatol Ther. 2020 Nov;33(6):e13959. doi: 10.1111/dth.13959, PMID 32618400.
Liu Y, Tortora G, Ryan ME, Lee HM, Golub LM. Potato dextrose agar antifungal susceptibility testing for yeasts and molds: evaluation of phosphate effect on antifungal activity of CMT-3. Antimicrob Agents Chemother. 2002 May;46(5):1455-61. doi: 10.1128/AAC.46.5.1455-1461.2002, PMID 11959582.